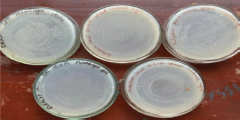

1. INTRODUCTION
Agriculture is one among the primary sectors of the economy and is defined as the science, art, and practice of cultivating plants and livestock [1,2]. It is the primary source of livelihood for about 58% of India’s population. To meet the need for food requirements farmers are using different varieties of pesticides. Organophosphates are one of the most important chemicals used for crop protection and to control vector-transmitted diseases. The primary mode of action of organophosphates is on the nervous system. Malathion, Methyl-parathion, Diazinon, Endosulfan, Dimethoate, Chlorpyrifos, Quinalphos, Profenofos, and Monocrotophos are some examples of organophosphates. In India, there is a steady increase in the use of organophosphates and a decrease is seen in the use of organochlorines. Organophosphatesare resistant to natural putrefaction and biodegradation, resulting in the emergence of these chemicals. Andra Pradesh is the state that is the biggest user of chemical pesticides, which uses 20% of the entirety of pesticides in the realm [3]. These pesticides are banned in many countries, but are used in India [4]. Among organophosphates the most extensively used pesticide is Quinalphos (QP: O,O-diethyl O-quinoxalin-2-yl phospharothioate) due to its efficiency. Quinalphos can be used over a wide variety of plants to control a wide range of pesticides. The boons resulting from the use of pesticides are undisputed, but the residues from the applied pesticides remain in the environment and pose a serious threat to animal and human life. There is much evidence that shows these pesticides cause harmful effects on the environment and life forms [5–7]. Soil microbes play an important role in the degradation of pesticides. They are responsible for the decomposition of degradable materials in the soil. The rate of degradation is mainly influenced by factors such as soil texture [8], soil pH [9], mode of action of the pesticide, chemical structure, and so on. Only 1% of the applied pesticide affects the intended pests and the rest reaches the environment polluting soil, water, and biota. The long-term persistence of these pesticides may directly or indirectly affect soil enzyme activities and physiological characteristics of non-target soil microflora including plant growth-promoting rhizobacteria, that eventually reduce the performance of several crop plants [10–12]. Owing to the large-scale production and use of quinalphos, their persistence in the environment, and their toxicity, it is important to find out new and unexploited microorganisms for degrading Quinalphos. To enhance degradation, we can make use of indigenous microorganisms that are already a part of the natural soil community. American Academy of Microbiology defined Bioremediation as the exploitation of living organisms to lessen or purge ecological perils formed due to the accretion of noxious chemicals or other perilous dissipate. It is an effective method to treat xenobiotic compounds like pesticides in soil; it is eco-friendly and has been used successfully in many countries [13,14]. Isolating strains that are capable of degrading higher concentrations of quinalphos is important so as to increase the efficiency of pesticide degradation.
Cash crop cultivation is becoming more popular in emerging countries with agriculture-based economies, such as India. However, a wide range of insects, from vermin to borers to root-feeding insects, are liable pro significant quantitative and qualitative losses in commercial crops. Pests, diseases, and weeds are all factors that affect crop productivity and quality. As a result, a variety of agrochemicals are routinely employed to protect farms. Farmers use more insecticidal applications to tackle the pest problem in order to maximize crops. However, the widespread use of these agrochemicals results in a massive build-up of residues in the environment. As a result of the uptake and accrual of these hazardous substances in the provisions shackle and consumption water, it poses a significant environmental health risk. Organophosphorus pesticide quinalphos is at the top of the list for controlling insects such as flea beetles, thrips, and so on.
Organophosphate pesticide is a class of very poisonous heterogeneous compounds to facilitate phosphoric acid derivative as a structural component and are commonly employed pro plant guard as well as pest control. In the region nearly 140 organophosphate chemicals are utilized as pesticides furthermore plant growth regulators [15], and they are found in over 100 different brands of commercially available pesticides (such as Malathion, Quinalphos, Diazinon, Dichlorvos, Paraoxon, and Parathion). The ability of organophosphorus insecticides to seep from dirt and taint earth water [16], otherwise, if inert, to persevere on the pinnacle soil and loudening to dangerous echelon in the dirt, posing a threat to microbes, flora, fauna, and human, is a solemn ecological hitch [17].
Organophosphate pesticides are neurotoxins that cause a variety of clinical effects by blocking acetylcholine esterase (AchE) in the fundamental and fringe nervous systems [18] in the form of acetylcholine alternates [19]. OPs have also been shown to have genotoxic and carcinogenic effects in recent investigations [20]. The toxicological effects of QP have been thoroughly studied in rats and other animals [21]. The pesticide QP was given to antenatal rats at levels of 1.5 mg kg−1 body weight, which inhibited AChE bustle in the fetal brain and placenta, demonstrating that the pesticide might be transferred to fetuses [22]. QP inhibits the bustle of testicular steroidogenic enzymes, resulting in germ cell degeneration and sperm count reduction [23]. Quinalphos residues have been found in soil for up to 40 days [24].
Biochemical handling, reprocessing, pyrolysis, incineration, and landfills are among the traditional procedures used to remediate organophosphate-contaminated sites, but they are inefficient, costly, and can also result in the creation of harmful intermediates [25]. The photo degradation of quinalphos in the existence of sunbeams and infrared radiation has been investigated [26]. Nevertheless, petite is known for the biodegradation of quinalphos by dirt microorganisms, which play a significant part in pesticide detoxification in the milieu.
Bioremediation, as demarcated by the American Academy of Microbiology, is the use of living organisms to minimalize or eradicate ecological menace striggered by the accrual of noxious substances or other perilous wildernesses. Because of its eco friendliness, bioremediation methods for treating xenobiotic substances like pesticides in dirt have gotten a proportion of consideration, and they've been employed successfully in a lot of countries. As a result, the seclusion of aboriginal microbes proficient in metabolizing organophosphate substances from insecticide-contaminated soil has gotten substantial interest [13,14].
Some bacterial species have been shown to degrade organophosphate insecticides using enzymes (phosphotriesterase) [27–30]. Nearly, some of the bacterial genera known from loam that can breakdown pesticides in runny media comprise Pseudomonas, Bacillus, Flavobacterium, Arthrobacter, and Xanthobacter [31].
For the high operational stability and accelerated rate of degradation of the biodegradative process, and for high cell density, and availability in continuous reactors [32]. Entrapment and adsorption procedures can be used to immobilize microorganisms in a variety of media. Microbial cells that had been immobilized were employed to produce valuable compounds and degrade xenobiotics [33]. The technique of immobilized microbe has received a lot of attention in previous studies. However, not much is known about the immobilized microorganism technique's ability to degrade quinalphos in soil. As per an outcome, bacterial immobilization technology resolves to be a protuberant subject in organic and eco-friendly investigations. Moreover, the epigenome comprising different mechanisms, e.g., DNA methylation, remodeling, histone tail modifications, chromatin microRNAs, and long non-coding RNAs, interact with environmental factors such as nutrition, pathogens, and climate to influence the expression profile of genes and the emergence of specific phenotypes [33–35]. Multi-level interactions between the genome, epigenome, and environmental factors might occur [36,37]. Furthermore, numerous lines of evidence suggest the influence of epigenome variation on health and production [1,34,38]. The expression of eukaryotic genes is temporarily and multidimensionally controlled [39]. Only a relatively small set of the entire genome is expressed in each type of tissue, and the expression of genes depends on the stage of development [40,41]. Therefore, gene expression is specific to each tissue [42]. In addition, the amount of gene products that are made in the same tissue as well as in other tissues that make up that product regulates the expression of that gene [41,43]. One of the basic activities is the study of genes and proteins related to economic traits and their study at the cellular or chromosomal level [2]. Thus, the aim of the current study clearly shows that the isolated organisms could be potentially used for biodegradation.
2. MATERIALS AND METHODS
2.1. Soil Samples Collection
Soil samples were collected from two different (soils) fields of Vazhayoor Panchayath, Malappuram district, Kerala, which has a history of farming activities for more than 30 years. Soil samples are collected from 10 to 20 cm depth and put in antiseptic polythene bags and were transferred aseptically to the laboratory. Soil samples were air dried to remove the excess water.
2.2. Reagents and Chemicals
Ekalux (Quinalphos 25% EC) pesticide used for the study was bought from the market and was diluted according to instructions given by the retailer. DPAAP (diazotized para aminoacetophenone) 0.1% (m/v) solution of the reagent was prepared by liquifying 500 mg of p- aminoacetophenonein 50 ml ethanol. This 10 ml of this reagent, ml of 1% sodium nitrite in hydrochloric acid was added and the solution was reserved in a brown bottle and stored in cold.
2.3. Screening of Quinalphos Degrading Bacteria
Minimal broth Davis with Ekalux as the sole carbon source was used and basal minimal agar with different concentrations of pesticides was used for acclimatization of bacterial isolate. For initial screening, Minimal broth Davis was prepared and poured into a conical flask. Ekalux pesticide was diluted according to the instructions from the farmers. 50 μl of diluted ekalux was added to the flask and was shaken well. 5 g of the soil collected from fields of Vazhayur was added to the flask and was incubated for 24 hours in a shaker incubator. Minimal agar medium plates were prepared and after sterilization were enriched with 0.1 ekalux as the sole carbon source, and it was inoculated with culture from minimal broth Davis and incubated at RT for 24–48 hours. The growth was observed after 48 hours. Concurrently, the culture from the conical flask was swabbed onto a nutrient agar plate by streaking and was stored as the master culture.
2.4. Identification and Characterization of Bacterial Isolates
The 10, isolates were identified based on morphological study and biochemical characterization [34]. Bergey’s manual [44] was rummage-sale as a reference to identify the isolates. Microscopic features were recorded for all colonies, color, size, and shape then further staining process were done. Isolates were analyzed for motility test by Hanging drop method, oxidase test, catalase test, indole test, methyl red, Voges Proskauer test, citrate utilization test, urease test, and triple sugar iron (TSI) agar test [38].
2.4.1. Motility test by hanging drop method
A clean glass cover slip was taken and applied vaseline on its four corners using a toothpick. A drop of bacterial broth culture was placed at the center of cover slip. A clean cavity slide was taken and placed over the cover slip and inverted in such a way that the drop hung into the cavity of the slide. It was then observed under 40X objective of a bright field microscope.
2.4.2. Oxidase test
A loopful of organisms was added to the given Oxidase disc. The color of the disc was observed.
2.4.3. Catalase test
A small amount of the organism colony was directly transferred to a clean glass slide using a toothpick or a sterile loop or needle. Then, added 1 to 2 drops of hydrogen peroxide and observed for bubbles.
2.4.4. Indole test
Sterilized test tubes containing 4 ml of tryptophan broth were prepared. The tubes were inoculated aseptically with the isolated organisms and incubated at 37°C for 24–28 hours. After incubation, 0.5 ml of Kovac's reagent was added to each broth culture, and the presence or absence of a ring was observed.
2.4.5. Methyl red and Voges proskauer test
Inoculated the MRVP broth with a pure culture of the organism and incubated at 35°C–37°C for a minimum of 48 hours at room temperature, 5 to 6 drops of methyl red reagent was added to each broth culture, and the color change was observed.
2.4.6. Citrate utilization test
A well-isolated colony is taken from a culture with the help of a sterile inoculating needle. The citrate agar tubes are inoculated by streaking the surface of the slant. The cap of the test tubes should be left loosened to ensure adequate aeration. The tubes are then incubated aerobically at 35°C–37°C. The test tubes should be examined daily for 4 days before discarding the result as a negative. The color change was observed.
2.4.7. Urease test
A sterile urease agar slant was prepared. Streaked the surface of a urease agar slant with the isolated culture. Leave the cap on loosely and incubate the tube at 35°C–37°C in room temperature. Examine for the development of a pink color.
2.4.8. TSI agar test
TSI agar slants were prepared aseptically. Inoculated TSI slants by first stabbing through the center of the medium to the bottom of the tube and then streaking the surface of the agar slant, incubated the tube at 35°C–37°C at room temperature for 18–24 hours and examining the reaction of the medium.
2.5. 16S rRNA Gene Amplification and Phylogeny Analysis
Molecular characterization of secluded bacterial strains was based on 16S rRNA conserved gene sequences using bacterial 27F and 1492R primers. The DNA of the isolates was extracted using a standard protocol followed by the Sigma Aldrich DNA Extraction Kit. The targeted gene sequence was amplified by polymerase chain reaction (Initial denaturation at 95°C for 5 minutes followed by 30 cycles each at 94°C for 45 seconds, at 52°C annealing for 45 seconds, and at 72°C extension for 45 seconds, followed with final elongation at 72°C for 10 minutes) method, and the size of the amplified fragments (1,200 base pairs) was evaluated by 1% gel electrophoresis. The amplified samples were sent for sequencing, and the retrieved nucleotide sequences were phylogenetically studied using MEGA software. Bacterial isolates were further confirmed at the species level by BLAST search using GenBank/EMBL database using the BLAST tool. To authorize free access to these strains, 16S rRNA gene sequences succumbed to the GenBank database with accession numbers [37,45].
2.6. Acclimatization of Enterobacter cloacae
The pre-isolated bacteria were revived by sub culturing in Nutrient agar, followed by acclimatization of cells to higher quinalphos concentration in minimal agar media, prior to immobilization and optimization studies. Acclimatization was carried out by inoculating the revived bacterial culture into five different flasks containing 20 ml minimal broth along with any one of the different pre-determined concentrations of pesticide (2, 4, 6, 8, and 10 ml); incubated at room temperature in shaker incubator for 24 hours. Acclimatized cells were isolated by spread plating bacterial cultures from 2, 4, 6, 8, and 10 ml pesticide-containing flasks onto minimal agar plates having five different concentrations 20, 40, 60, 80, and 100 μl of pesticides, respectively. After inoculation, plates were left to incubate at room temperature for 24 hours, and observed for growth.
2.7. Immobilization of E. cloacae
Immobilization was carried out by agar encapsulation of E. cloacae. A solution of sodium alginate 3% v/v in 50 mM sodium phosphate buffer (pH 7.0) was prepared by heating the buffer to 50°C. To 5 ml of this, once cooled, 1 ml of 0.5 McFarland standard culture (1.5 × 108 cells/ml) was mixed in. Thus, the final concentration of the bacterial culture becomes 0.2 ml (3 × 107 cells/ml). Another solution of 1 M of calcium chloride was prepared and the temperature was brought down to ~ 4°C. Sodium alginate solution with the bacterial culture was taken into a sterile syringe and was allowed to drop into chilled calcium chloride solution by applying gentle pressure to the piston of the syringe by keeping it at a distance from the CaCl2 solution surface. Gel beads were filtered out washed and dried using germ-free purified water and Whatman’s No.1 filter paper respectively [43].
2.8. Optimization of Biodegradation of Quinalphos by E. cloacae
Optimization studies were carried out to find the optimal conditions for maximum biodegradation for both directly inoculated systems and those that were inoculated with immobilized bacteria.
2.8.1. Effect of pH
The effect of the initial pH of the media on the degradation of quinalphos was checked. Here, the initial pH of the minimal media was adjusted to 4, 7, and 9. The inoculum of 1.0 ml was adjusted to 0.5 McFarland standard (1.5 * 108 CFU/ml) and was inoculated in a 20 ml medium containing 1 ml of quinalphos. After incubation for 18 hours, samples were removed and checked for pesticides. Similarly, the effect of the initial pH of media on quinalphos biodegradation by immobilized cell culture was determined by inoculation 2.19 g (Dry weight of gel beads obtained from 6 ml of sodium alginate-bacterial culture solution) of immobilized gel beads into three different flasks containing a mixture of 20 ml sterile minimal broth and 1 ml of quinalphos; each having different pH of 4, 7, and 9, respectively. All flasks were incubated for 24 hours at 37°C in a shaker incubator. Incubation was followed by centrifugation to obtain a cell-free sample for measuring O.D(nm) was noted.
2.8.2. Effect of temperature
Effect incubation temperature on the biodegradative capacity of the bacteria was observed by inoculating 2.19 g (dry weight of gel beads obtained from 6 ml of sodium alginate-bacterial culture solution) immobilized gel beads in to three different flasks containing a mixture of 20 ml sterile minimal broth and 1 ml of quinalphos; each having different temperatures of 25°C, 35°C, and 45°C separately. All flagons were incubated for 24 hours at 37°C in a shaker incubator. Incubation was followed by centrifugation to obtain a cell-free sample for measuring the OD value of each sample was noted.
2.8.3. Effect of glucose as additional source of carbon
Effect incubation temperature on the biodegradative capacity of the bacteria was observed by inoculating 2.19 g (Dry weight of gel beads obtained from 6 ml of sodium alginate-bacterial culture solution) immobilized gel beads in to three different flasks containing a mixture of 20 ml sterile minimal broth and 1 ml of Ekalux; each having dissimilar Glucose concentrations of 0.5%, 1.0%, and 1.5%, respectively. All flasks were incubated for 24 hours at 37°C in a shaker incubator. Incubation was tailed by centrifugation to obtain a cell-free sample for measuring the O.D value of each sample was noted.
2.8.4. Effect of optimal conditions on biodegradation
To 20 ml sterile minimal broth (in two separate flasks) having 1% glucose as an additional carbon source, 3 ml of Ekalux was added. This was inoculated free cell culture in one flask and immobilized cells in another flask. O.D was measured after incubation at 35°C temperature and pH 7.
2.9. Estimation of Quinalphos
DPAAP was used as a color reagent for the Photometric estimation of the Quinalphos. 0.1% (m/v) substances were formulated by dissolving 500 mg of p-aminoacetophenone in 5 ml ethanol; to which, 1 ml of 1% Sodium nitrite was assorted with hydrochloric acid. The ensuing solution was stored in a dark bottle and kept under refrigeration when not in use [40]. 1 ml of DPAAP reagent was to each sample subjected to optimization, mixed well, and incubated at 0°C–5°C for 15 minutes till the color changed from yellow to reddish-violet. Absorbance was measured at 560 nm compared to the reagent blank [42].
3. RESULTS AND DISCUSSION
3.1. Screening and Seclusion of Quinalphos Degrading Bacteria
Microbial strains that were able to grow in minimal broth with Quinalphos as a sole carbon source were lonely from dirt. Out of 10, isolates one isolated organism showed the ability to grow in the presence of Quinalphos. The culture from the broth was transferred onto minimal agar plates by spread plate technique to get isolated colonies (Fig. 1).
3.2. Biochemical Characterization of Isolated Strain
The isolated organism’s Gram-stained smear showed pink-colored Gram-negative rod-shaped cells (Fig. 2). The organism was motile, non-sporing, and non-capsulated (Table 1).
3.3. Molecular Identification of Bacterial Isolates
Based on the BLAST analysis (Fig. 3) through the sequencing data after 16SrRNA gene sequence analysis followed by phylogenetic tree construction (Fig. 4) by neighbor joining, the sample (Culture B) showed a 99.42% similarity with E. cloacae (NCBI Accession No: CP035738.1).
 | Figure 1. Isolated organism on minimal agar plate. [Click here to view] |
 | Figure 2. Gram-negative (-) rods. [Click here to view] |
 | Table 1. Biochemical characteristics of the isolates. [Click here to view] |
3.4. Revival and Acclimatization
Cell culture was successfully revived successfully in nutrient agar. The acclimatized organism showed its ability to grow well in higher micro liter concentrations of pesticide, up to 100 μl of Ekalux concentration (Figs. 5 and 6).
3.5. Immobilization
After immobilization, the washed and dried gel beads were collected and the total dry weight was measured. The total dry weight obtained from 6 ml of sodium alginate-bacterial culture solution was 2.19 g (Fig. 7).
3.6. Biodegradation of Quinalphos by E. cloacae
Results of optimization of the following variables of biodegradation by both free cell culture and immobilized cells were noted and compared with each other and with a standard calibration graph, and graphs were plotted (Fig. 8).
 | Figure 3. Gel image of 16s rRNAamplicon for E. cloacae. [Click here to view] |
3.6.1. Effect of pH
Biodegradation by E. cloacae could be observed in all of three different pH levels at different rates in both cases. Maximum turbidity of the medium was seen in media having pH 7, indicating maximum growth in both cases. On photometric analysis with DPAAP reagent at 560 nm, residual quinalphos was found to be lowest in pH 7, with the least O.D value. Hence, pH 7 was selected as the optimum pH out of the three. At optimum pH, immobilized cells gave 7.8% better results than free cells (Table 2).
3.6.2. Effect of temperature
All three temperatures supported the growth of E. cloacae and the biodegradation of quinalphos. Of the three temperatures tested (Table 3), in both free cell and immobilized cell cultures, the best result was observed in the sample incubated at 35°C; the least degradation could be seen when incubated at 25°C. From the results, it can be assumed that the rate of degradation increases till 35°C–37°C, then decreases as the temperature increases further. This was observed to be true for both cases. Hence, out of the above three temperatures, 35°C was considered optimum. At optimum temperature, immobilized cells performed 12.4% more efficiently than free cell cultures.
3.6.3. Effect of glucose as additional source of carbon
When the impact of an added carbon source, glucose in the biodegradation of Quinalphos by E. cloacae, the following conclusions were made: Of the three concentrations of glucose (0.5%, 1.0%, 1.5%), 1% of glucose was found to support maximum bacterial growth. The best degradation out of the three was also observed to be in the sample containing 1% glucose since it showed the least amount of residual quinalphos under photometric analysis (Table 4). This was found to be true in both cases. Thus, 1% glucose concentration was selected as optimum. At 1% glucose concentration, there immobilized cells gave 8.2% better results than free cells.
Similar results have been reported in other studies regarding the biosynthesis of pesticides. Gangireddigary [46] described an optimum temperature of 35°C–37°C, and pH of 6.5–7.5 in biodegradation of quinalphos by Bacillus thuringiensis. Glucose concentration did not have any notable effect on pesticide degradation by B. thuringiensis [35]. Biodegradation of quinalphos through Ochrobactrum sp. strain HZM was found to give superlative results at pH-7 and 25°C temperature by in-silico analysis through response surface methodology [36].
 | Figure 4. Phylogenetic tree is constructed using 16S rRNA gene sequence of E. cloacae. [Click here to view] |
 | Figure 5. Revived culture on nutrient agar plate with 10 μl Ekalux. [Click here to view] |
| Figure 6. Acclimatized E. cloacae in minimal agar plates with different concentrations of Ekalux (20, 40, 60, 80, and 100 μl). [Click here to view] |
 | Figure 7. Immobilized gel beads. [Click here to view] |
 | Figure 8. Calibration curve of standard quinalphos. [Click here to view] |
In recent times when the consequences of unregulated and indiscriminate use of pesticides are being experienced globally, demand for proper detoxification of soil and water is increasing. Several studies are being conducted to find an efficient way of Xenobiotic degradation. Numerous pesticides or amalgamations of pesticides are feast in governing pests in fields [47]. Naturally occurring or man-made chemicals are used to protect the plants, as well as to add aesthetic value to plant and its products [48]. These chemicals remain in the soil and they effect target as well as non-target organisms. The residues of these pesticides persevere in the dirt and milieu for extended retro and cause harmful effects to animal and human life forms. A soil microbe helps in the degradation of pesticides. Various physico-chemical parameters influence biodegradation of Quinalphos [49]. On optimizing pH, it was originating that the ideal pH for quinalphos degradation is 7. It is probable that the crucial enzymes that cause quinalphos degradation partake in their optimal enzymatic activity at pH 7. Furthermore, the organisms cannot abide by pH values underneath 4.0 and directly above 9.0 as it distresses the metabolic pathway and denatures the proteins which also attests to be lethal [1]. Singh and Walker found the maximum degradation rate of fenamiphos and chlorpyrifos by moreover a BEP consortium or Enterobacter sp. was detected at 35°C. According to the US Environmental Protection Agency, Organophosphate pesticides such as Quinalphos, Parathion, and Chlorpyrifos are considered as some of the most widely used insecticides in the 21st century. Several studies have been conducted on biodegradation of Quinalphos by bacteria such as Ochrobactrum sp. strain HZM, B. thuringiensis, and Pseudomonas spp [46,50]. From the present study, it was observed that pH 7, 35°C temperature, and 1% glucose concentration appeared to give the best results; and as anticipated, Immobilization of viable cells of E. cloacae gave a significantly higher rate of degradation than free cell culture [51,52]. The investigation has numerous insinuations in bioremediation of pesticides meanwhile it is massively modified to the milieu and can overwhelm some of the disadvantages of bio augmentation, where non-indigenous microorganisms are traded into dirtied sites that have to contend with the natural microbial civic. However, it may be essential to study the consequence of further pesticides contrary to the secluded strain for its proficiency to be used counter to miscellaneous pesticides [53].
 | Table 2. Results of photometric analysis of quinalphos biodegradation by E. cloacae at different pH. [Click here to view] |
 | Table 3. Results of photometric analysis of quinalphos biodegradation by E. cloacae at different temperatures in °C. [Click here to view] |
 | Table 4. Effect of glucose concentration on Ekalux biodegradation by E. cloacae. [Click here to view] |
4. CONCLUSION
The frequent use of pesticides will lead to several properties on the soil microbial community and thereby diminish the fertility of the soil. Likewise, in some cases, pesticides may slaughter more than their envisioned aims which include essential microbes. In bioremediation, microorganisms that can worsen pesticides in situ are used. A well-organized bacterial strain that can degrade prime impurity to a trifling level is vital for an efficacious bioremediation technique. In the present investigation a bacterium proficient in degrading pesticide Quinalphos, was secluded from farmland dirtied with pesticide, and the isolate was identified as E. cloacae. The above study leads to a probable utensil of erecting a bacterial strain that might be beneficial in the bioremediation of pesticides. From the obtained data, it was concluded that E. cloacae could degrade quinalphos with the most efficiency when immobilized (approx. 11%); and a pH of 7, temperature of 35°C, and glucose concentration of 1% were employed. The process is eco-friendly and environmentally acceptable as it uses indigenous microorganisms which are already a part of soil microflora for Quinalphos degradation.
5. ACKNOWLEDGMENT
The authors are thankful to the Kerala State Council for Science and Technology and Environment for (KSCSTE, Government of Kerala) for providing the initial financial support under the Student Project Scheme (File No./Letter no: 00190 SPS 65/2021/ KSCSTE), Dated: 13-03-2023.
6. CONFLICTS OF INTEREST
The authors report no financial or any other conflicts of interest in this work.
7. ETHICAL APPROVALS
This study does not involve experiments on animals or human subjects.
8. AUTHOR CONTRIBUTIONS
All authors made substantial contributions to conception and design, acquisition of data, or analysis and interpretation of data; took part in drafting the article or revising it critically for important intellectual content; agreed to submit to the current journal; gave final approval of the version to be published; and agree to be accountable for all aspects of the work. All the authors are eligible to be an author as per the international committee of medical journal editors (ICMJE) requirements/guidelines.
9. DATA AVAILABILITY
The authors confirm that the data supporting the findings of this study are available within the article.
10. PUBLISHER’S NOTE
All claims expressed in this article are solely those of the authors and do not necessarily represent those of the publisher, the editors and the reviewers. This journal remains neutral with regard to jurisdictional claims in published institutional affiliation.
11. Use of artificial intelligence (AI)-assisted technology
The authors declares that they have not used artificial intelligence (AI)-tools for writing and editing of the manuscript, and no images were manipulated using AI.
REFERENCES
1. Safaei SMH, Dadpasand M, Mohammadabadi M, Atashi H, Stavetska R, Klopenko N, et al. An Origanum majorana leaf diet influences Myogenin gene expression, performance, and Carcass characteristics in lambs. Animals 2022;13(1):14.
2. Safaei SMH, Mohammadabadi M, Moradi B, Kalashnyk O, Klopenko N, Babenko O. Role of Fennel (Foeniculum vulgare) seed powder in increasing testosterone and IGF1 gene expression in the testis of lamb. Gene Expr 2024;23(2):98–105.
3. Gupta PK. Guidelines for cholinesterase-inhibiting pesticide residues in food. In: Gupta RC (ed.). Toxicology of organophosphate and carbamate compounds, Elsevier, New York, NY, pp 643–54, 2006.
4. Mishra A, Devi Y. Histopathological alterations in the brain (optictectum) of the fresh water teleost Channa punctatus in response to acute and subchronic exposure to the pesticide chlorpyrifos. Acta Histochem 2014;116:176–81.
5. Forget G. Balancing the need for pesticides with the risk to human health. In: Forget G, Goodman T, de Villiers A, (eds.). Impact of pesticide use on health in developing countries, IDRC, Ottawa, Canada, p 2, 1993.
6. Igbedioh SO. Effects of agricultural pesticides on humans, animals and higher plants in developing countries. Arch Environ Health 1991;46:218.
7. Jeyaratnam J. Health problems of pesticide usage in the third world. B M J 1985;42:505.
8. Xing B, Pignatello JJ. Dual-mode sorption of low-polarity compounds in glassy poly (vinyl chloride) and soil organic matter. Environ Sci Technol 1997;31:792–9.
9. Walker CH, Hopkin SP, Sibly RM, Peakall DB. Principles of ecotoxicology. T&F STM, London, UK, p 386, 2001.
10. Hussain S, Siddique T, Saleem M, Arshad M, Khalid A. Impact of pesticides on soil microbial diversity, enzymes and biochemical reactions. Adv Agronomy 2009;102:159–200.
11. Angelini R, De Morais RJ, Catella AC, Resende EK, Libralato S. Aquatic food webs of the oxbow lakes in the Pantanal: a new site for fisheries guaranteed by alternated control? Ecol Modell 2013;253:82–96.
12. Hernandez PP, Undurraga C, Gallardo VE, Mackenzie N, Allende ML. Sublethal concentrations of waterborne copper induce cellular stress and cell death in zebrafish embryos and larvae. Biol Res 2011;44:7–15.
13. Mulchaldini P, Mulchaldini A, Kaneva I, Chen W. Biosensor for directdetermination of organophosphate nerve agents. I. Potentiometric enzyme electrode. Biosens Bioelectron 1999;14:77–85.
14. Richins RD, Kanera I, Mulchandani A, Chen W. Biodegradation of organophosphorus pesticides by surface-expressed organophosphorus hydrolase. Nature Biotechnol 1997;15:984–7.
15. Kang DG, Choi SS, Cha HJ. Enhanced biodegradation of toxic organophosphate compounds using recombinant E.coli with sec pathway driven periplasmic secretion of organophosphorous hydrolase. Biotechnol Prog 2006;22:406–10.
16. Kookana R, Correll R, Miller RB. Pesticide impact rating index- a pesticide risk indicator for water quality. J Water Air Soil Pollut Focus 2005;5:45–6.
17. Amaikiri MA. Microbial degradation of soil applied herbicides. Nig J Microl 1982;2:17–21.
18. Babu GVAK, Reddy BR, Golla N, Sethunathan S. Persistence of quinalphos and occurance of its primary metabolites in soil. Bull Environ Contam Toxicol 1998;60(5):724–34.
19. Jokanovic M. Neurotoxic effects of organophosphorus pesticides and possible association with neurodegenerative diseases in man: a review. J Toxicol 2018;410:125–31.
20. Kaushik P, Kaushik G. An assessment of structure and toxicity correlation in organophosphate pesticides. J Hazard Mater 2007;143(1-2):102–11.
21. Subramaneyaan M, Jain S, Yadav C, Arora VK, Banerjee BD, Ahmed RS. Quinalphos induced oxidative stress and histoarcheitectural alterations in adult male albino rats. J Environ Toxicol Pharmacol 2012;34:673–8.
22. Srivastava MK, Raizada RB, Dikshit TS. Fetotoxic response of technical quinalphos in rats. Vet Hum Toxicol 1992;34(2):131–3.
23. Ray A, Chatterjee S, Bagchi P, Das TK, Deb C. Effect of quinalphose on testicular steroidogenesis in rats. Arch Environ Contam Toxicol 1992;20(2):163–8.
24. Gajbhiye VT, Agnihotri NP, Gupta RK. Effects of formulation on the dissipation of quinalphos from soil and water. J Entomol Res 1995;19:295–300.
25. Felsot AS, Racke KD, Hamilton DJ. Disposal and degradation of pesticide waste. Rev Environ Contam Toxicol 2003;177:123–200.
26. Gonçalves C, Dimou A, Sakkas V, Alpendurada MF, Albanis TA. Photolytic degradation of quinalphose in natural waters and on soil matrices under solar light. J Chemosphere 2006;64(8):1375–82.
27. Mulbry WW, Karns JS, Kearney PC. Identification of a plasmid borned parathion hydrolase gene from Flavobacterium sp. By southern hybridization with opd from Pseudomonas diminuta. Appl Environ Microbiol 1986;51:926–30.
28. Gopal S, Rastogi V, Ashman W, Mulbry W. Mutagenesis of organophosphorus hydrolase to enhance hydrolysis of the nerve agent VX. Biochem Biophys Res Commun 2000;279:516–9.
29. Chen-Goodspeed M, Sogorb MA, Wu F, Hong SB, Raushel FM. Structural determinants of the substrate and stereochemical specificity of phosphotriesterase. Biochemistry 2001;40:1325–31.
30. Kim K, Tsay OG, Atwood DA, Churchill DG. Destruction and detection of chemical warfare agents. Chem Rev 2011;111:5345–403.
31. Gossel AT, Bricker JD. Principle of toxicology. 3rd edition, Raven Press, New York, NY, 1994.
32. Cassidy MB, Lee H, Trevors JT. Environmental applications of immobilized microbial cells: a review. J Ind Microbiol 1996;16:79–101.
33. Barazandeh A, Mohammadabadi MR, Ghaderi-Zefrehei M, Nezamabadipour H. Predicting CpG islands and their relationship with genomic feature in cattle by hidden Markov Model Algorithm. Iran J Appl Anim Sci 2016a;6(3):571–9.
34. Barazandeh A, Mohammadabadi MR, Ghaderi-Zefrehei M, Nezamabadipour H. Genome-wide analysis of CpG islands in some livestock genomes and their relationship with genomic features. Czech J Anim Sci 2016b;61:487.
35. Noori AN, Behzadi MRB, Mohammadabadi MR. Expression pattern of Rheb gene in Jabal Barez Red goat. Indian J Anim Sci 2017;87(11):1375–8.
36. Saadatabadi LM, Mohammadabadi M, Nanaei HA, Ghanatsaman ZA. Unraveling candidate genes related to heat tolerance and immune response traits in some native sheep using whole genome sequencing data. Small Rumin Res 2023;225:e107018.
37. Jafari Ahmadabadi SAA, Askari-Hemmat H, Mohammadabadi M, Asadi M, Mansouri M. The effect of Cannabis seed on DLK1 gene expression in heart tissue of Kermani lambs. Agric Biotechnol J 2023;15(1):217–34.
38. Bordbar F, Mohammadabadi M, Jensen J, Xu L, Li J, Zhang L. Identification of candidate genes regulating carcass depth and hind leg circumference in simmental beef cattle using Illumina Bovine Beadchip and next-generation sequencing. Animals 2022;12(9):1103.
39. Shahsavari M, Mohammadabadi M, Khezri A, Borshch O, Babenko O, Kalashnyk O. Effect of Fennel (Foeniculum vulgare) seed powder consumption on insulin-like growth factor 1 gene expression in the liver tissue of growing lambs. Gene Expr 2022;21(2):21–6.
40. Mohammadabadi M, Masoudzadeh SH, Khezri A, Kalashnyk O, Stavetska RV, Klopenko NI, et al. Fennel (Foeniculum vulgare) seed powder increases Delta-Like Non-Canonical Notch Ligand 1 gene expression in testis, liver, and humeral muscle tissues of growing lambs. Heliyon 2021;7(12):e08542.
41. Shokri S, Khezri A, Mohammadabadi M, Kheyrodin H. The expression of MYH7 gene in femur, humeral muscle and back muscle tissues of fattening lambs of the Kermani breed. Agric Biotechnol J 2023;15(2):21.
42. Mohammadinejad F, Mohammadabadi M, Roudbari Z, Sadkowski T. Identification of key genes and biological pathways associated with skeletal muscle maturation and hypertrophy in Bos taurus, Ovis aries, and Sus scrofa. Animals 2022;12(24):3471.
43. Mohammadabadi M, Golkar A, Askari Hesni M. The effect of fennel (Foeniculum vulgare) on insulin-like growth factor 1 gene expression in the rumen tissue of Kermani sheep. Agric Biotechnol J 2023;15(4):239–56.
44. Garrity G, Staley JT, Boone DR, De Vos P, Goodfellow M, Rainey FA. Bergey's manual of systematic bacteriology: the photobacteria. Springer Science & Bussiness Media, Berlin, Germany, p 2, 2006.
45. Qin J, Li R, Raes J, Arumugam M, Burgdorf KS, Manichanh C. A human gut microbial gene catalogue established by metagenomic sequencing. Nature 2010;464:59–65.
46. Gangireddygari VSR, Kalva PK, Ntushelo K, Bangeppagari M, Djami Tchatchou A, Bontha RR. Influence of environmental factors on biodegradation of quinalphos by Bacillus thuringiensis. Environ Sci Eur 2017;29(11):1–10.
47. Joshi BK, Bhatta MR, Ghimire KH, Khanal M, Gurung SB, Dhakal R, et al. Released and promising crop varieties of mountain agriculture in Nepal (1959-2016). LI-BIRD, Pokhara; NARC, Kathmandu and Bioversity International, Pokhara, Nepal, 2017.
48. Janghel EK, Rai JK, Rai MK, Gupta VK. A new sensitive spectrophotometric determination of cypermethrin insecticide in environmental and biological samples. J Braz Chem Soc 2007;18(3):590–4.
49. Nagamani A, Kunwar IK. Handbook of soil fungi. In: Indra K, Manoharachary C (eds.). I.K. International, Bhiwandi, India, 2009.
50. Talwar MP, Mulla SI, Ninnekar HZ. Biodegradation of organophosphate pesticide quinalphos by Ochrobactrum sp. strain HZM. J Appl Microbiol 2014;117(5):1283–92.
51. D’Souza SF. Trends in immobilized enzyme and cell technology. Indian J Biotechnol 2002;1:321–8.
52. Annadurai G, Balan MS, Murugesan T. Design of experiments in the biodegradation of phenol using immobilized Pseudomonas pictorium on activated carbon. Bioproc Eng 2000;22:102–7. 53. Punitha M, Caroline Rose J. Biodegradation of organophosphorous pesticide using immobilized esterase and toxicity assessment. J Glob Biosci 2018;7(1):5331–41.